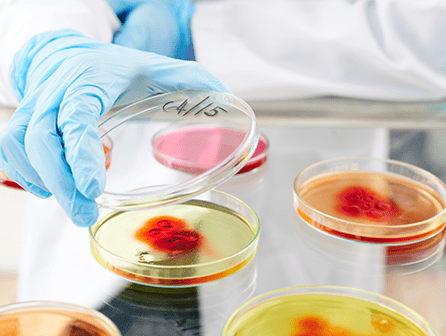

SOMOS LA VOZ DE CLIENTE
Distinción y Cuidado Personalizado en Importación, Seguros Vip y Análisis Genético de Excelencia. Superamos expectativas, creamos conexiones significativas, y aseguramos tu futuro saludable y próspero.
Sobre nosotros
VIP: visión, ideas y proyectos

Transformando Industrias con Innovación y Alianzas Estratégicas en Comercio Internacional, Tecnología
VIP (Visión, Ideas y Proyectos) es una empresa puntera, dirigida por un equipo con amplia experiencia en comercio internacional, tecnología y deporte. Ofrecemos una amplia gama de servicios, aprovechando nuestra amplia red de contactos de alto perfil, con una visión tecnológica y soluciones ambientales. Nuestra misión es dar forma a las industrias a través de tecnologías innovadoras y asociaciones estratégicas.
Vip Import & Export
Importación y exportación de alimentos y
champagne premium

Explora el Placer Gourmet: Importación Exquisita de Alimentos y Champagne
Explora una Experiencia Gastronómica Excepcional con nuestra selección meticulosa de alimentos selectos y champagne de alta calidad, cuidadosamente elegidos para deleitar los paladares más exigentes mientras promueven la salud y el bienestar. Nos enorgullece ofrecer una oferta culinaria única, donde cada bocado y sorbo es una fusión perfecta de sabor y nutrición. Trabajamos estrechamente con productores internacionales, asegurando estándares superiores en cada producto ofrecido, con un enfoque destacado en la calidad y la salud. Ya sea para tu restaurante, hotel o negocio de catering, te proporcionamos ingredientes exclusivos que no solo deleitarán, sino que también contribuirán a una vida más saludable para tus clientes
Seguros Vip
Cuidando tu bienestar con seguros
médicos privados

VIP-ON: Tu Aliado en Salud para una Tranquilidad Total
Los seguros médicos privados de VIP-ON brindan la máxima tranquilidad y confianza a sus asegurados, con coberturas completas que incluyen medicina primaria, especialidades reconocidas, diagnósticos, tratamientos, urgencias nacionales e internacionales, hospitalización e intervenciones quirúrgicas. Además, garantizan un segundo diagnóstico médico en casos de enfermedades graves, brindando seguridad ante cualquier problema de salud serio. Con acceso a una amplia red de profesionales médicos de renombre, VIP-ON adapta sus pólizas a las necesidades individuales de cada asegurado. Además, los clientes disfrutan de beneficios exclusivos, como el chat médico iSalud, disponible las 24 horas para consultas con especialistas. Confía en VIP-ON, tu aliado en salud.
Análisis Genético
Previniendo para un futuro
saludable

Anticipa tu Bienestar: VIP-ON Te Ayuda a Predecir, Prevenir y Prever
En VIP-ON, entendemos que la clave para una vida plena y saludable radica en la capacidad de predecir, prevenir y prever. Nuestros servicios de diagnóstico integral y prevención de enfermedades están diseñados para ayudarte a anticiparte a los problemas de salud, permitiéndote vivir mejor y más. Con tecnología innovadora y un enfoque centrado en el bienestar, te acompañamos en cada paso hacia un futuro más saludable y prometedor. Vive con la tranquilidad de saber que estás tomando medidas proactivas para cuidar tu salud con VIP-ON.
Noticias
Información relacionada
el mundo de la exclusividad
Contacta con nosotros
Estamos aquí para responder tus preguntas y discutir posibles colaboraciones. Completa el formulario y nos comunicaremos contigo pronto. ¡Gracias por elegir VIP!